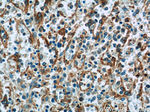
PLEKHO2 Antibody in Immunohistochemistry (Paraffin) (IHC (P))

Search
Proteintech
PLEKHO2 Polyclonal Antibody
{{$productOrderCtrl.translations['antibody.pdp.commerceCard.promotion.promotions']}}
{{$productOrderCtrl.translations['antibody.pdp.commerceCard.promotion.viewpromo']}}
{{$productOrderCtrl.translations['antibody.pdp.commerceCard.promotion.promocode']}}: {{promo.promoCode}} {{promo.promoTitle}} {{promo.promoDescription}}. {{$productOrderCtrl.translations['antibody.pdp.commerceCard.promotion.learnmore']}}
产品信息
21356-1-AP
种属反应
宿主/亚型
分类
类型
抗原
偶联物
形式
浓度
规格
纯化类型
保存液
内含物
保存条件
运输条件
产品详细信息
Immunogen sequence: TRDRVRGGQ RRRPPTRVHL KEVASAASDG LLRLDLDVPD SGPPVFAPSN HVSEAQPRET PRPLMPPTKP FLAPETTSPG DRVETPVGER APTPVSASSE VSPESQEDSE TPAEEDSGSE QPPNSVLPDK LKVSWENPSP QEAPAAESAE PSQAPCSETS EAAPREGGKP PTPPPKILSE KLKASMGEMQ ASGPPAPGTV QVSVNGMDDS PEPAKPSQAE GTPGTPPKDA TTSTALPPWD LPPQFHPRCS SLGDLLGEGP RHPLQPRERL YRAQLEVKVA SEQTEKLLNK VLGSEPAPVS AETLLSQAVE QLRQATQVLQ EMRDLGELSQ EAPGLREKRK ELVTLYRRSA P (141-490 aa encoded by BC008744)
靶标信息
Pleckstrin homology domain-containing proteins family O member 2 (PLEKHO2)'s function remains largely unknown. Genetic polymorphisms of PLEKHO2 contribute to diabetic retinopathy (DR) development. Functional prediction analysis strengthened the likelihood of participation of PLEKHO2 in the development of DR (Eric C. Han et al., 2012).
仅用于科研。不用于诊断过程。未经明确授权不得转售。
篇参考文献 (0)
生物信息学
蛋白别名: PH domain-containing family O member 2; PH domain-containing family Q member 1; PH domain-containing protein; PH domain-containing protein homolog; pleckstrin homology domain containing, family Q member 1; Pleckstrin homology domain-containing family O member 2; Pleckstrin homology domain-containing family Q member 1; TRIP; unnamed protein product
基因别名: AI840980; PLEKHO2; PLEKHQ1; PP1628; PP9099
UniProt ID: (Human) Q8TD55, (Mouse) Q8K124
Entrez Gene ID: (Human) 80301, (Mouse) 102595